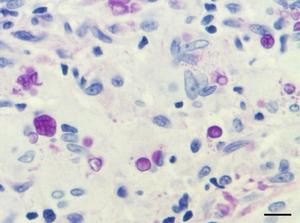
在顯微鏡下看到的具有致命危險的微藻類Prototheca cutis

概述
顯微鏡下看到具有致命危險的微藻類Prototheca cutis
顯微鏡下看到具有致命危險的微藻類Prototheca cutis生長環境
除了南極洲以外,人們可能會在世界各地的土壤和水裡發現P. cutis。因為這種微生物的生存能力很強,可在經過消毒的環境下倖存下來,它們在污水和家庭垃圾里繁衍生息,農村環境對它們的生存更加有利。這名日本患者已經被成功治癒,他是目前已知的唯一一名P. cutis受害者。但是日本東京帝京大學的醫學真菌學家、這項研究的領導者槙村浩一認為,最新發現的這種水藻的行為,可能跟有害的微藻類一樣。微藻類是在世界各地的水域裡發現的單細胞有機體。
接觸感染
 由微藻類感染引起的組織損傷
由微藻類感染引起的組織損傷在嚴重情況下,微藻類感染會慢慢演變成具有致命風險的敗血症(細菌進入血液)或者腦膜炎(大腦和脊髓周圍的組織發炎)。據該研究說,身體虛弱的住院患者經常會出現這種情況。
治療措施
1、由於微藻類感染非常罕見,因此這方面的治療方法並不多。目前只能用抗真菌藥物進行治療。即使水藻不是真菌,但事實證明,抗真菌藥物治癒了近59%的嚴重的微藻類感染患者的疾病。2、那些不治身亡的患者的感染情況更加嚴重。不過他說,世界上的大部分微藻類“都是無害的”,這種情況使新發現的P. cutis成為一種非常重要和具有吸引力的研究對象。
